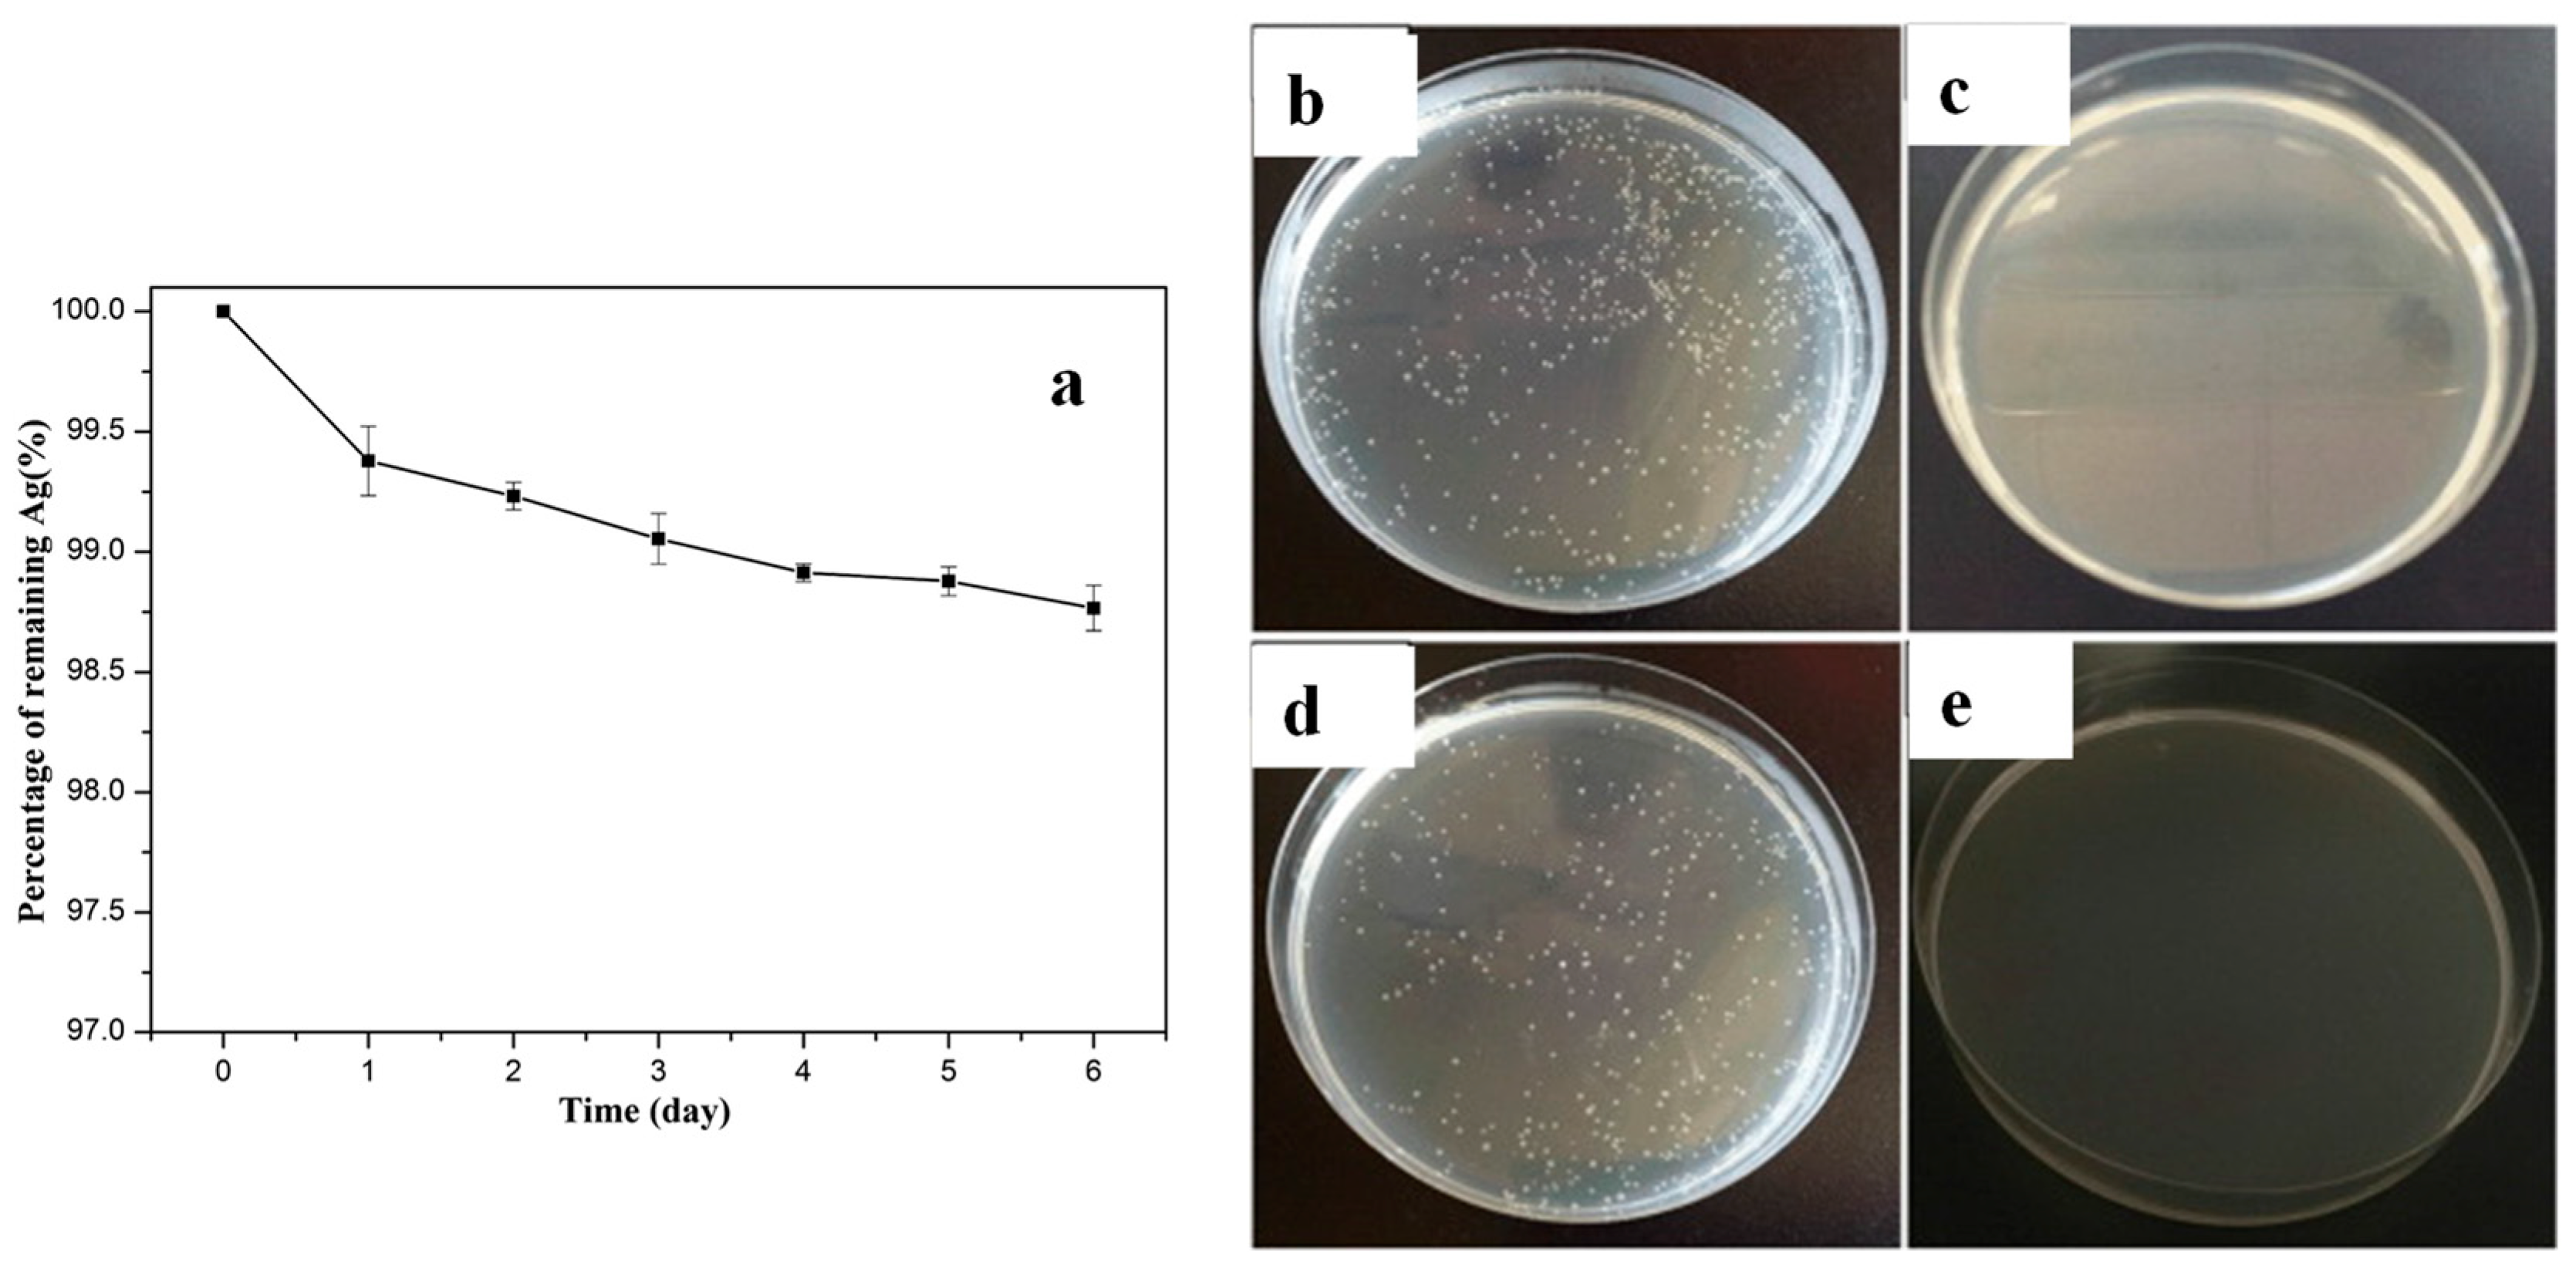
Polymers 16 01611 g004

In Situ Generation of Nanoparticles on and within Polymeric Materials
Abstract
1. Introduction
2. Discussion
2.1. Metal NPs
2.1.1. Role of Polymers to NP Growth
2.1.2. In Situ Deposition on Textiles Fibres
2.1.3. In Situ Deposition on Polymeric Substrates
2.1.4. In Situ Formation within a Polymer Matrix
2.1.5. In Situ Generation of Ag NPs via Melt Extrusion
2.2. Carbon-Based NPs
2.2.1. Carbon Nanotubes (CNTs) and Graphene Oxide (GO)
2.2.2. Carbon Dots (C-Dots)
2.3. Titanium Dioxide and Silica-Based NPs
2.4. Layered Double Hydroxide (LDH) and Hectorite
2.5. Lignin and Hydroxyapatite
2.6. In Situ NP Formation Simultaneously with Additional Major Structural Modifications
3. Conclusions and Outlook
Funding
Conflicts of Interest
References
- Wei, H.G.; Wang, H.; Li, A.; Cui, D.P.; Zhao, Z.N.; Chu, L.Q.; Wei, X.; Wang, L.; Pan, D.; Fan, J.C.; et al. Multifunctions of Polymer Nanocomposites: Environmental Remediation, Electromagnetic Interference Shielding, and Sensing Applications. ChemNanoMat Chem. Nanomater. Energy Biol. 2020, 6, 174–184. [Google Scholar] [CrossRef]
- Ates, B.; Koytepe, S.; Ulu, A.; Gurses, C.; Thakur, V.K. Chemistry, Structures, and Advanced Applications of Nanocomposites from Biorenewable Resources. Chem. Rev. 2020, 120, 9304–9362. [Google Scholar] [CrossRef] [PubMed]
- Kalia, S.; Kango, S.; Kumar, A.; Haldorai, Y.; Kumari, B.; Kumar, R. Magnetic polymer nanocomposites for environmental and biomedical applications. Colloid Polym. Sci. 2014, 292, 2025–2052. [Google Scholar] [CrossRef]
- Zhang, M.; Li, Y.; Su, Z.; Wei, G. Recent advances in the synthesis and applications of graphene-polymer nanocomposites. Polym. Chem. 2015, 6, 617–6124. [Google Scholar] [CrossRef]
- Huang, J.; Zhou, J.; Liu, M. Interphase in Polymer Nanocomposites. JACS Au 2022, 2, 280–291. [Google Scholar] [CrossRef] [PubMed]
- Bailey, E.J.; Winey, K.I. Dynamics of polymer segments, polymer chains, and nanoparticles in polymer nanocomposite melts: A review. Prog. Polym. Sci. 2020, 105, 101242. [Google Scholar] [CrossRef]
- Supova, M.; Martynkova, G.; Barabaszova, K. Effect of Nanofillers Dispersion in Polymer Matrices: A Review. Sci. Adv. Mater. 2011, 3, 1–25. [Google Scholar] [CrossRef]
- Verma, C.; Hussain, C.M.; Quraishi, M.A. Functionalized Nanomaterials for Corrosion Mitigation: Synthesis, Characterization, and Applications; American Chemical Society: Cambridge, MA, USA, 2022. [Google Scholar]
- Sanità, G.; Carrese, B.; Lamberti, A. Nanoparticle Surface Functionalization: How to Improve Biocompatibility and Cellular Internalization. Front. Mol. Biosci. 2020, 7, 587012. [Google Scholar] [CrossRef]
- Kumar, Y.; Sinha, A.S.K.; Nigam, K.D.P.; Dwivedi, D.; Sangwai, J.S. Functionalized nanoparticles: Tailoring properties through surface energetics and coordination chemistry for advanced biomedical applications. Nanoscale 2023, 15, 614–675. [Google Scholar] [CrossRef]
- Kamal, A.; Ashmawy, M.; S, S.; Algazzar, A.M.; Elsheikh, A.H. Fabrication techniques of polymeric nanocomposites: A comprehensive review. Proc. Inst. Mech. Eng. Part C J. Mech. Eng. Sci. 2022, 236, 4843–4861. [Google Scholar] [CrossRef]
- Hayrapetyan, S.; Kelarakis, A.; Estevez, L.; Lin, Q.; Dana, K.; Chung, Y.; Giannelis, E.P. Non-toxic poly(ethylene terephthalate)/clay nanocomposites with enhanced barrier properties. Polymer 2012, 53, 422–426. [Google Scholar] [CrossRef]
- Yan, D.; Zhang, H.; Jia, Y.; Hu, J.; Qi, X.; Zhang, Z.; Yu, Z. Improved Electrical Conductivity of Polyamide 12/Graphene Nanocomposites with Maleated Polyethylene-Octene Rubber Prepared by Melt Compounding. ACS Appl. Mater. Interfaces 2012, 4, 4740–4745. [Google Scholar] [CrossRef]
- Kelarakis, A.; Yoon, K. Optical transparency in a polymer blend induced by clay nanofillers. Eur. Polym. J. 2008, 44, 3941–3945. [Google Scholar] [CrossRef]
- Darwish, M.S.A.; Mostafa, M.H.; Al-Harbi, L.M. Polymeric Nanocomposites for Environmental and Industrial Applications. Int. J. Mol. Sci. 2022, 23, 1023. [Google Scholar] [CrossRef] [PubMed]
- Kelarakis, A.; Yoon, K.; Sics, I.; Somani, R.H.; Hsiao, B.S.; Chu, B. Uniaxial deformation of an elastomer nanocomposite containing modified carbon nanofibers by in situ synchrotron X-ray diffraction. Catal. Lett. 2005, 46, 5103–5117. [Google Scholar] [CrossRef]
- Kelarakis, A.; Hayrapetyan, S.; Ansari, S.; Fang, J.; Estevez, L.; Giannelis, E.P. Clay nanocomposites based on poly(vinylidene fluoride-co-hexafluoropropylene): Structure and properties. Polymer 2010, 51, 469–474. [Google Scholar] [CrossRef]
- Gopika, R.; Arun, K.; Ramesan, M.T. In-situ polymerization of polythiophene/silicon carbide nanocomposites for gas sensing and optoelectronic devices. J. Mater. Res. Technol. 2024, 30, 1288–1300. [Google Scholar] [CrossRef]
- Zhao, C.; Hu, G.; Justice, R.; Schaefer, D.W.; Zhang, S.; Yang, M.; Han, C.C. Synthesis and characterization of multi-walled carbon nanotubes reinforced polyamide 6 via in situ polymerization. Polymer 2005, 46, 5125–5132. [Google Scholar] [CrossRef]
- Ma, J.; Li, Y.; Yin, X.; Xu, Y.; Yue, J.; Bao, J.; Zhou, T. Poly(vinyl alcohol)/graphene oxide nanocomposites prepared by in situ polymerization with enhanced mechanical properties and water vapor barrier properties. RSC Adv. 2016, 6, 49448–49458. [Google Scholar] [CrossRef]
- Weimer, M.W.; Chen, H.; Giannelis, E.P.; Sogah, D.Y. Direct Synthesis of Dispersed Nanocomposites by in Situ Living Free Radical Polymerization Using a Silicate-Anchored Initiator. J. Am. Chem. Soc. 1999, 121, 1615–1616. [Google Scholar] [CrossRef]
- Nurakhmetova, Z.A.; Azhkeyeva, A.N.; Klassen, I.A.; Tatykhanova, G.S. Synthesis and Stabilization of Gold Nanoparticles Using Water-Soluble Synthetic and Natural Polymers. Polymers 2020, 12, 2625. [Google Scholar] [CrossRef] [PubMed]
- Koczkur, K.M.; Mourdikoudis, S.; Polavarapu, L.; Skrabalak, S.E. Polyvinylpyrrolidone (PVP) in nanoparticle synthesis. Dalton Trans. 2015, 44, 17883–17905. [Google Scholar] [CrossRef] [PubMed]
- Xia, X.; Zeng, J.; Oetjen, L.K.; Li, Q.; Xia, Y. Quantitative Analysis of the Role Played by Poly(vinylpyrrolidone) in Seed-Mediated Growth of Ag Nanocrystals. J. Am. Chem. Soc. 2012, 134, 1793–1801. [Google Scholar] [CrossRef] [PubMed]
- Maji, T.; Banerjee, S.; Biswas, M.; Mandal, T.K. In situ synthesis of ultra-small platinum nanoparticles using a water soluble polyphenolic polymer with high catalytic activity. RSC Adv. 2014, 4, 51745–51753. [Google Scholar] [CrossRef]
- Anees Ahmad, S.; Sachi Das, S.; Khatoon, A.; Tahir Ansari, M.; Afzal, M.; Saquib Hasnain, M.; Kumar Nayak, A. Bactericidal activity of silver nanoparticles: A mechanistic review. Mater. Sci. Energy Technol. 2020, 3, 756–769. [Google Scholar] [CrossRef]
- Patch, D.; Koch, I.; Peloquin, D.; O’Carroll, D.; Weber, K. Development and validation of a method for the weathering and detachment of representative nanomaterials from conventional silver-containing textiles. Chemosphere 2021, 284, 131269. [Google Scholar] [CrossRef] [PubMed]
- Pasricha, A.; Jangra, S.L.; Singh, N.; Dilbaghi, N.; Sood, K.N.; Arora, K.; Pasricha, R. Comparative study of leaching of silver nanoparticles from fabric and effective effluent treatment. J. Environ. Sci. 2012, 24, 852–859. [Google Scholar] [CrossRef] [PubMed]
- Montes-Hernandez, G.; Di Girolamo, M.; Sarret, G.; Bureau, S.; Fernandez-Martinez, A.; Lelong, C.; Eymard Vernain, E. In Situ Formation of Silver Nanoparticles (Ag-NPs) onto Textile Fibers. ACS Omega 2021, 6, 1316–1327. [Google Scholar] [CrossRef] [PubMed]
- Jaswanth, S.; Umamahesh, M.; Reddy, G.R.; Ramanamurthy, G.V.; Prasad, A.; Rajulu, A.V. In situ generation of antibacterial copper nanocomposite fabrics by bioreduction with Moringa oliefiera leaf extract. Inorg. Nano-Met. Chem. 2021, 51, 259–266. [Google Scholar] [CrossRef]
- Mamatha, G.; Varada Rajulu, A.; Madhukar, K. In Situ Generation of Bimetallic Nanoparticles in Cotton Fabric Using Aloe Vera Leaf Extract, as a Reducing Agent. J. Nat. Fibers 2020, 17, 1121–1129. [Google Scholar] [CrossRef]
- Shahid, M.; Cheng, X.; Tang, R.; Chen, G. Silk functionalization by caffeic acid assisted in-situ generation of silver nanoparticles. Dye. Pigment. 2017, 137, 277–283. [Google Scholar] [CrossRef]
- Shahid, M.; Zhou, Y.; Cheng, X.; Zar, M.S.; Chen, G.; Tang, R. Ferulic acid promoted in-situ generation of AgNPs@silk as functional colorants. J. Clean. Prod. 2018, 176, 736–744. [Google Scholar] [CrossRef]
- Kishanji, M.; Mamatha, G.; Madhuri, D.; Suresh Kumar, D.; Vijaya Charan, G.; Ramesh, S.; Jadhav, V.; Madhukar, K. Preparation and characterization of cellulose/in situ generated silver nanoparticle composite films prepared using Pongamia pinnata leaf extract as a reducing and stabilizing agent. Inorg. Nano-Met. Chem. 2021, 51, 1207–1213. [Google Scholar] [CrossRef]
- Gollapudi, V.R.; Mallavarapu, U.; Seetha, J.; Akepogu, P.; Amara, V.R.; Natarajan, H.; Anumakonda, V. In situ generation of silver and silver oxide nanoparticles on cotton fabrics using Tinospora cordifolia as bio reductant. SN Appl. Sci. 2020, 2, 508. [Google Scholar]
- Sadanand, V.; Rajini, N.; Varada Rajulu, A.; Satyanarayana, B. Preparation of cellulose composites with in situ generated copper nanoparticles using leaf extract and their properties. Carbohydr. Polym. 2016, 150, 32–39. [Google Scholar] [CrossRef] [PubMed]
- He, J.; Kunitake, T.; Nakao, A. Facile In Situ Synthesis of Noble Metal Nanoparticles in Porous Cellulose Fibers. Chem. Mater. 2003, 15, 4401–4406. [Google Scholar] [CrossRef]
- Yu, Y.; Zhou, Z.; Huang, G.; Cheng, H.; Han, L.; Zhao, S.; Chen, Y.; Meng, F. Purifying water with silver nanoparticles (AgNPs)-incorporated membranes: Recent advancements and critical challenges. Water Res. 2022, 222, 118901. [Google Scholar] [CrossRef] [PubMed]
- Dong, C.; Wang, Z.; Wu, J.; Wang, Y.; Wang, J.; Wang, S. A green strategy to immobilize silver nanoparticles onto reverse osmosis membrane for enhanced anti-biofouling property. Desalination 2017, 401, 32–41. [Google Scholar] [CrossRef]
- Ben-Sasson, M.; Lu, X.; Bar-Zeev, E.; Zodrow, K.R.; Nejati, S.; Qi, G.; Giannelis, E.P.; Elimelech, M. In situ formation of silver nanoparticles on thin-film composite reverse osmosis membranes for biofouling mitigation. Water Res. 2014, 62, 260–270. [Google Scholar] [CrossRef]
- Suresh, D.; Goh, P.S.; Wong, T.W.; Zhang, L.; Ismail, A.F. In-situ complexation of silver nanoparticle on thin film composite reverse osmosis membrane for improving desalination and anti-biofouling performance. Desalination 2024, 569, 117040. [Google Scholar] [CrossRef]
- Guo, L.; Liu, Q.; Li, G.; Shi, J.; Liu, J.; Wang, T.; Jiang, G. A mussel-inspired polydopamine coating as a versatile platform for the in situ synthesis of graphene-based nanocomposites. Nanoscale 2012, 4, 5864. [Google Scholar] [CrossRef]
- Degli Esposti, M.; Fabbri, P.; Morselli, D. Self-Assembled PMMA Porous Membranes Decorated with In Situ Synthesized ZnO Nanoparticles with UV-Tunable Wettability. Macromol. Mater. Eng. 2020, 305, 2000017. [Google Scholar] [CrossRef]
- Subair, R.; Tripathi, B.P.; Formanek, P.; Simon, F.; Uhlmann, P.; Stamm, M. Polydopamine modified membranes with in situ synthesized gold nanoparticles for catalytic and environmental applications. Chem. Eng. J. 2016, 295, 358–369. [Google Scholar] [CrossRef]
- Ziollo, R.F.; Giannelis, E.P.; Weinstein, B.A.; O’horo, M.P.; Ganguly, B.N.; Mehotra, V.; Russel, M.W.; Huffman, D.R. Matrix-mediated synthesis of nanocrystalline γ-Fe2O3: A new optically transparent magnetic material. Science 1992, 257, 219–223. [Google Scholar] [CrossRef]
- Hossain, S.; Rahman, M.; Nahar, Y.; Rahman, A.; Sharafat, M.K.; Hossain, M.; Ochiai, B.; Elaissari, A.; Ahmad, H. A simple in situ synthesis of iron oxide magnetic nanoparticles embedded in thermosensitive polymer for DNA capture. J. Mater. Res. 2020, 35, 2441–2450. [Google Scholar] [CrossRef]
- Ghosh, S.K.; Alam, M.M.; Mandal, D. The in situ formation of platinum nanoparticles and their catalytic role in electroactive phase formation in poly(vinylidene fluoride): A simple preparation of multifunctional poly(vinylidene fluoride) films doped with platinum nanoparticles. RSC Adv. 2014, 4, 41886–41894. [Google Scholar] [CrossRef]
- Mehrabanian, M.; Morselli, D.; Caputo, G.; Scarpellini, A.; Palazon, F.; Athanassiou, A.; Fragouli, D. Laser-induced in situ synthesis of Pd and Pt nanoparticles on polymer films. Appl. Phys. A 2016, 122, 1075. [Google Scholar] [CrossRef]
- Jeon, S.; Xu, P.; Zhang, B.; Mack, N.H.; Tsai, H.; Chiang, L.Y.; Wang, H. Polymer-assisted preparation of metal nanoparticles with controlled size and morphology. J. Mater. Chem. 2011, 21, 2550–2554. [Google Scholar] [CrossRef]
- Ledo-Suárez, A.; Puig, J.; Zucchi, I.A.; Hoppe, C.E.; Gómez, M.L.; Zysler, R.; Ramos, C.; Marchi, M.C.; Bilmes, S.A.; Lazzari, M.; et al. Functional nanocomposites based on the infusion or in situ generation of nanoparticles into amphiphilic epoxy gels. J. Mater. Chem. 2010, 2, 1135–1145. [Google Scholar] [CrossRef]
- Pan, J.; Zhang, Z.; Zhan, Z.; Xiong, Y.; Wang, Y.; Cao, K.; Chen, Y. In situ generation of silver nanoparticles and nanocomposite films based on electrodeposition of carboxylated chitosan. Carbohydr. Polym. 2020, 242, 116391. [Google Scholar] [CrossRef]
- Mascia, L.; Zhang, W.; Gatto, F.; Scarpellini, A.; Pompa, P.P.; Mele, E. In Situ Generation of ZnO Nanoparticles within a Polyethyleneimine Matrix for Antibacterial Zein Fibers. ACS Appl. Polym. Mater. 2019, 1, 1707–1716. [Google Scholar] [CrossRef]
- Santiago-Castillo, K.; Del Angel-López, D.; Torres-Huerta, A.M.; Domínguez-Crespo, M.A.; Palma-Ramírez, D.; Willcock, H.; Brachetti-Sibaja, S.B. Effect on the processability, structure and mechanical properties of highly dispersed in situ ZnO:CS nanoparticles into PVA electrospun fibers. J. Mater. Res. Technol. 2021, 11, 929–945. [Google Scholar] [CrossRef]
- Morselli, D.; Campagnolo, L.; Prato, M.; Papadopoulou, E.L.; Scarpellini, A.; Athanassiou, A.; Fragouli, D. Ceria/Gold Nanoparticles in Situ Synthesized on Polymeric Membranes with Enhanced Photocatalytic and Radical Scavenging Activity. ACS Appl. Nano Mater. 2018, 1, 5601–5611. [Google Scholar] [CrossRef]
- Parida, D.; Simonetti, P.; Frison, R.; Bülbül, E.; Altenried, S.; Arroyo, Y.; Balogh-Michels, Z.; Caseri, W.; Ren, Q.; Hufenus, R.; et al. Polymer-assisted in-situ thermal reduction of silver precursors: A solventless route for silver nanoparticles-polymer composites. Chem. Eng. J. 2020, 389, 123983. [Google Scholar] [CrossRef]
- Anzar, N.; Hasan, R.; Tyagi, M.; Yadav, N.; Narang, J. Carbon nanotube—A review on Synthesis, Properties and plethora of applications in the field of biomedical science. Sens. Int. 2020, 1, 100003. [Google Scholar] [CrossRef]
- Tsierkezos, N.G.; Ritter, U.; Nugraha Thaha, Y.; Knauer, A.; Fernandes, D.; Kelarakis, A.; McCarthy, E.K. Boron-doped multi-walled carbon nanotubes as sensing material for analysis of dopamine and epinephrine in presence of uric acid. Chem. Phys. Lett. 2018, 710, 157–167. [Google Scholar] [CrossRef]
- Beg, M.S.; Gibbons, E.N.; Gavalas, S.; Holden, M.A.; Krysmann, M.; Kelarakis, A. Antimicrobial coatings based on amine-terminated graphene oxide and Nafion with remarkable thermal resistance. Nanoscale Adv. 2024, 6, 2594–2601. [Google Scholar] [CrossRef]
- Hong, E.H.; Lee, K.-H.; Oh, S.H.; Park, C.-G. In-Situ Synthesis of Carbon Nanotubes on Organic Polymer Substrates at Atmospheric Pressure. Adv. Mater. 2002, 14, 676–679. [Google Scholar] [CrossRef]
- Zaman, A.; Orasugh, J.T.; Banerjee, P.; Dutta, S.; Ali, M.S.; Das, D.; Bhattacharya, A.; Chattopadhyay, D. Facile one-pot in-situ synthesis of novel graphene oxide-cellulose nanocomposite for enhanced azo dye adsorption at optimized conditions. Carbohydr. Polym. 2020, 246, 116661. [Google Scholar] [CrossRef] [PubMed]
- Kelarakis, A. From highly graphitic to amorphous carbon dots: A critical review. MRS Energy Sustain. 2014, 1, 2. [Google Scholar] [CrossRef]
- Stachowska, J.D.; Murphy, A.; Mellor, C.; Fernandes, D.; Gibbons, E.N.; Krysmann, M.J.; Kelarakis, A.; Burgaz, E.; Moore, J.; Yeates, S.G. A rich gallery of carbon dots based photoluminescent suspensions and powders derived by citric acid/urea. Sci. Rep. 2021, 11, 10554. [Google Scholar] [CrossRef] [PubMed]
- Krysmann, M.J.; Kelarakis, A.; Giannelis, E.P. Photoluminescent carbogenic nanoparticles directly derived from crude biomass. Green Chem. 2012, 14, 3141–3145. [Google Scholar] [CrossRef]
- Fernandes, D.; Heslop, K.A.; Kelarakis, A.; Krysmann, M.J.; Estevez, L. In situ generation of carbon dots within a polymer matrix. Polymer 2020, 188, 122159. [Google Scholar] [CrossRef]
- Lian, F.; Wang, C.; Wu, Q.; Yang, M.; Wang, Z.; Zhang, C. In situ synthesis of stretchable and highly stable multi-color carbon-dots/polyurethane composite films for light-emitting devices. RSC Adv. 2020, 10, 1281–1286. [Google Scholar] [CrossRef] [PubMed]
- Ahn, J.; Pak, S.; Song, Y.; Kim, H. In-situ synthesis of carbon dot at cellulose nanofiber for durable water treatment membrane with high selectivity. Carbohydr. Polym. 2021, 255, 117387. [Google Scholar] [CrossRef] [PubMed]
- Wang, S.; Yi, Z.; Zhao, X.; Zhou, Y.; Gao, C. Aggregation suppressed thin film nanocomposite (TFN) membranes prepared with an in situ generation of TiO2 nanoadditives. RSC Adv. 2017, 7, 26136–26144. [Google Scholar] [CrossRef]
- Musto, P.; Ragosta, G.; Scarinzi, G.; Mascia, L. Toughness enhancement of polyimides by in situ generation of silica particles. Polymer 2004, 45, 4265–4274. [Google Scholar] [CrossRef]
- Shen, H.; Wang, S.; Xu, H.; Zhou, Y.; Gao, C. Preparation of polyamide thin film nanocomposite membranes containing silica nanoparticles via an in-situ polymerization of SiCl4 in organic solution. J. Membr. Sci. 2018, 565, 145–156. [Google Scholar] [CrossRef]
- Xu, H.; Cao, X.; Shi, Y.; Cong, T.; Liu, H.; Gao, Y. In situ formation of POSS layer on the surface of polyimide film and anti-atomic oxygen of SiO2/POSS coatings. Prog. Org. Coat. 2023, 182, 107703. [Google Scholar] [CrossRef]
- Aladpoosh, R.; Montazer, M. In Situ Nanoassembly of Mg-Al Layered Double Hydroxide on Polyester Fabric Surface: Mechanism, Tunable Wettability, and Boosted Thermal Features. Ind Eng Chem Res 2019, 58, 16532–16540. [Google Scholar] [CrossRef]
- Aladpoosh, R.; Montazer, M. Functionalization of cellulose fibers alongside growth of 2D LDH platelets through urea hydrolysis inspired Taro wettability. Carbohydr. Polym. 2022, 275, 118584. [Google Scholar] [CrossRef] [PubMed]
- Carrado, K.A.; Xu, L. In Situ Synthesis of Polymer−Clay Nanocomposites from Silicate Gels. Chem. Mater. 1998, 10, 1440–1445. [Google Scholar] [CrossRef]
- Pasquier, E.; Mattos, B.D.; Belgacem, N.; Bras, J.; Rojas, O.J. Lignin Nanoparticle Nucleation and Growth on Cellulose and Chitin Nanofibers. Biomacromolecules 2021, 22, 880–889. [Google Scholar] [CrossRef] [PubMed]
- Mollazadeh, S.; Javadpour, J.; Khavandi, A. In situ synthesis and characterization of nano-size hydroxyapatite in poly(vinyl alcohol) matrix. Ceram. Int. 2007, 33, 1579–1583. [Google Scholar] [CrossRef]
- Mollazadeh, S.; Javadpour, J.; Khavandi, A. Biomimetic synthesis and mechanical properties of hydroxyapatite/poly (vinyl alcohol) nanocomposites. Adv. Appl. Ceram. 2007, 106, 165–170. [Google Scholar] [CrossRef]
- Ryu, J.; Ku, S.H.; Lee, H.; Park, C.B. Mussel-Inspired Polydopamine Coating as a Universal Route to Hydroxyapatite Crystallization. Adv. Funct. Mater. 2010, 20, 2132–2139. [Google Scholar] [CrossRef]
- Estevez, L.; Kelarakis, A.; Gong, Q.; Da’as, E.H.; Giannelis, E.P. Multifunctional Graphene/Platinum/Nafion Hybrids via Ice Templating. J. Amer. Chem. Soc 2011, 133, 6122–6125. [Google Scholar] [CrossRef] [PubMed]
- Zhang, Z.; Zhang, L.; Wang, S.; Chen, W.; Lei, Y. A convenient route to polyacrylonitrile/silver nanoparticle composite by simultaneous polymerization–reduction approach. Polymer 2001, 42, 8315–8318. [Google Scholar] [CrossRef]
- Zang, L.; Qiu, J.; Yang, C.; Sakai, E. Preparation and application of conducting polymer/Ag/clay composite nanoparticles formed by in situ UV-induced dispersion polymerization. Sci. Rep. 2016, 6, 20470. [Google Scholar] [CrossRef]
- Singh, A.; Salmi, Z.; Joshi, N.; Jha, P.; Kumar, A.; Lecoq, H.; Lau, S.; Chehimi, M.M.; Aswal, D.K.; Gupta, S.K. Photo-induced synthesis of polypyrrole-silver nanocomposite films on N-(3-trimethoxysilylpropyl)pyrrole-modified biaxially oriented polyethylene terephthalate flexible substrates. RSC Adv. 2013, 3, 5506–5523. [Google Scholar] [CrossRef]
- Bhunia, S.K.; Nandi, S.; Manna, J.; Shikler, R.; Jelinek, R. Tuneable light-emitting carbon-dot/polymer flexible films prepared through one-pot synthesis. Nanoscale 2016, 8, 3400–3406. [Google Scholar] [CrossRef] [PubMed]

| Types of Nanoparticles | Inherent Characteristics | References |
|---|---|---|
| Au, Ag, Pt, Pd, ZnO, Cu, Fe2O3 and Ce/Au | Antimicrobial Antifouling Catalytic activity Colourants | [26,27,28,29,30,31,32,33,34,35,36,37,38,39,40,41,42,43,44,45,46,47,48,49,50,51,52,53,54,55] |
| CNTs, graphene oxide | Absorption capacity (Mechanical reinforcement) (Electronic conductivity) (Barrier properties) | [59,60] |
| C-dots | Fluorescence (Antimicrobial) (Antioxidant) | [64,65,66] |
| TiO2 | (Photocatalytic properties) | [67] |
| SiO2 | Mechanical reinforcement | [68,69] |
| POSS | Erosion protection (Low dielectric response) | [70] |
| LDH | Barrier properties | [71,72] |
| Hectorite | (Mechanical reinforcement) (Barrier properties) | [73] |
| Lignin | UV blocking Antioxidant activity | [74] |
| Hydroxyapatite | Bioadhesion Mechanical reinforcement | [75,76,77] |
Disclaimer/Publisher’s Note: The statements, opinions and data contained in all publications are solely those of the individual author(s) and contributor(s) and not of MDPI and/or the editor(s). MDPI and/or the editor(s) disclaim responsibility for any injury to people or property resulting from any ideas, methods, instructions or products referred to in the content. |
© 2024 by the author. Licensee MDPI, Basel, Switzerland. This article is an open access article distributed under the terms and conditions of the Creative Commons Attribution (CC BY) license (https://creativecommons.org/licenses/by/4.0/).
Share and Cite
Kelarakis, A. In Situ Generation of Nanoparticles on and within Polymeric Materials. Polymers 2024, 16, 1611. https://doi.org/10.3390/polym16111611
Kelarakis A. In Situ Generation of Nanoparticles on and within Polymeric Materials. Polymers. 2024; 16(11):1611. https://doi.org/10.3390/polym16111611
Chicago/Turabian StyleKelarakis, Antonios. 2024. "In Situ Generation of Nanoparticles on and within Polymeric Materials" Polymers 16, no. 11: 1611. https://doi.org/10.3390/polym16111611
APA StyleKelarakis, A. (2024). In Situ Generation of Nanoparticles on and within Polymeric Materials. Polymers, 16(11), 1611. https://doi.org/10.3390/polym16111611
